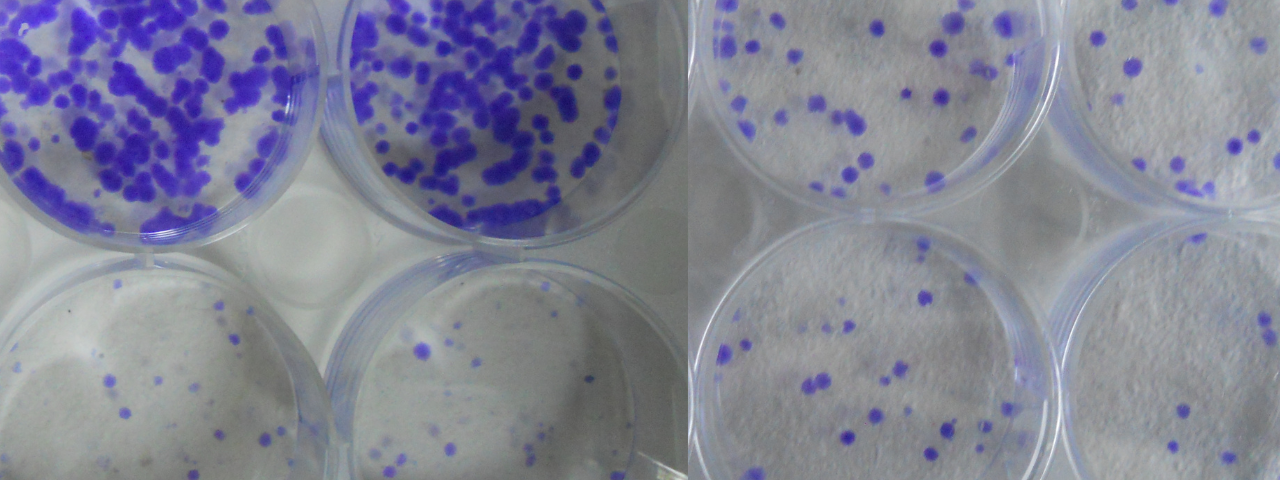
Welcome to RPS Cancer Lab

Prof. Rana P Singh
Vice-Chancellor
Gautam Buddha University
Greater Noida, India
Professor
School of Life Sciences
Jawaharlal Nehru University
New Delhi, India
Cancer Biology Group - JNU, led by Prof. Rana P. Singh at the School of Life Sciences, Jawaharlal Nehru University (JNU), New Delhi, specializes in pioneering research in cancer biology and therapeutic strategies. The lab focuses on unraveling the molecular mechanisms underlying cancer initiation, progression, and metastasis, employing a multidisciplinary approach that includes molecular biology, oxidative stress biology, cell signaling, tumor angiogenesis, and experimental therapeutics.
Key research areas involve investigating non-toxic, natural phytochemicals as potential anticancer agents, particularly emphasizing their chemopreventive and therapeutic properties. Utilizing advanced experimental platforms like in vitro cell cultures, in vivo animal models, and genetically amenable Drosophila melanogaster models, the lab seeks to identify pathways involved in oxidative stress regulation, apoptosis, angiogenesis, and immune modulation.
Prof. Singh also directs the Drug and Pharmaceuticals Research Program (DPRP) at JNU and leads the Center for Excellence in Ayurveda and Systems Medicine, which promotes integrative research combining traditional Ayurveda with modern biomedical sciences.
RPS Cancer Lab collaborates internationally, notably contributing to the establishment of the "Centre for Integrative Cancer Biology and Therapeutics" alongside institutions such as Stanford University and Oregon Health & Science University. Committed to translational research, the lab aims to develop safer, effective, and personalized cancer therapies.
Prof. Singh is currently serving as the Vice Chancellor of Gautam Buddha University, Greater Noida, Delhi NCR. He also supervises the research work in his laboratory at JNU.
Administrative Positions/Activities
Vice-Chancellor
Institution: Gautam Buddha University, Greater Noida, Uttar Pradesh, India
Duration: Feb 2025–present
Rector/Pro-VC
Institution: Jawaharlal Nehru University, New Delhi
Duration: 2017–2022
Dean of Students
Institution: Jawaharlal Nehru University, New Delhi
Duration: April 2016–May 2017
Dean of Students’ Welfare
Institution: Central University of Gujarat, Gandhinagar, Gujarat, India
Duration: 2011–2012
Chairman, Admission Committee
Institution: Central University of Gujarat, Gandhinagar, India
Duration: 2011
Dean, School of Life Sciences
Institution: Central University of Gujarat, Gandhinagar, Gujarat, India
Duration: 2010–2012
Dean, School of Environmental Sciences
Institution: Central University of Gujarat, Gandhinagar, Gujarat, India
Duration: 2011
Provost
Institution: Central University of Gujarat (CUG), Gandhinagar, Gujarat, India
Duration: 2010–2011
Warden (Senior/Mess/Health/Recreation)
Institution: Sabarmati Hostel, JNU, New Delhi
Duration: 2007–2010
Awards/Honors
Indo-US Science Technology Forum (IUSSTF) - Award for establishing "Centre for Integrative Cancer Biology and Therapeutics"
Institution/Organization:
Virtual Networked Centre - JNU and Stanford University
Period: 2019
ICMR International Fellowship for Young Biomedical Scientists
Institution/Organization:
University of California Riverside, USA
Period: 2013-14
Post-doctoral Trainee Award for Prostate Cancer Research
Institution/Organization:
U.S. Army Medical Research and Materiel Command, Department of Defense, USA
Period: 2003-05
Scholar-in-Training Award
Institution/Organization:
American Association for Cancer Research, Philadelphia, PA, USA
Period: 2002
Academic Career
Professor of Cancer Biology
Institution:
School of Life Sciences, Jawaharlal Nehru University, New Delhi, India
Year: 2012–present
Visiting Scientist
Institution:
University of California Riverside, CA, USA
Year: 2014 (Feb–June)
Professor-Adjunct
Institution:
School of Life Sciences, Central University of Gujarat, Gandhinagar, Gujarat, India
Year: 2012–2016
Professor
Institution:
School of Life Sciences, Central University of Gujarat, Gandhinagar, Gujarat, India
Year: 2010–2012
Associate Professor, Molecular Cancer Biology
Institution:
School of Life Sciences, Jawaharlal Nehru University, New Delhi, India
Year: 2006–2010
Assistant Professor - Research
Institution:
Department of Pharmaceutical Sciences, School of Pharmacy, University of Colorado Denver, CO, USA
Year: 2003–2006
Research Associate
Institution:
Department of Pharmaceutical Sciences, School of Pharmacy, University of Colorado and Health Sciences Center, Denver, CO, USA
Year: 2001–2003
Post-doctoral Research Fellow
Institution:
Center for Cancer Causation and Prevention, AMC Cancer Research Center, Lakewood, CO, USA
Year: 2000–2001
Other Professional Activities
Academic Committee Member
Organization/Location: CIMAP, Lucknow, India
Duration: 2019–21
Academic Committee Member
Organization/Location: NII, New Delhi, India
Duration: 2019–2021
Board Member
Organization/Location: SERB, Department of Science and Technology, Govt. of India
Duration: 2018–20
Academic Committee Member
Organization/Location: ICGEB, New Delhi, India
Duration: 2019
LEAP Program participant
Organization/Location: JNU, New Delhi and NUS, Singapore
Duration: Feb 2019
Chairman of Program Review Committee
Organization/Location: National Council for Science and Technology Communications, DST, Govt. of India
Duration: 2018
Council’s Nominee for Committee in Biological/Life Sciences
Organization/Location: IISER Kolkata, India
Duration: 2018
Academic Committee Member
Organization/Location: THSTI, Faridabad, Haryana, India
Duration: 2017–2019
Council’s Nominee for Committee in Biological/Life Sciences
Organization/Location: IISER Bhopal, India
Duration: 2017
Academic Committee Member
Organization/Location: Raman Research Institute, Bangalore, India
Duration: 2017–2019
Chairman, Selection Committee
Organization/Location: National Overseas Scholarship, Ministry of Tribal Affairs, Govt. of India
Duration: 2017
Member-Expert
Organization/Location: Faculty Selection Committee, J&K Public Service Commission, Jammu, India
Duration: 2017
Academic Committee Member
Organization/Location: Army Cadet College, IMA, Dehradun, UK, India
Duration: 2016
Academic Committee Member
Organization/Location: CSIR–CDRI, Lucknow, UP, India
Duration: 2016–2018
Member-Expert
Organization/Location: Selection Committee, Chinese Government Scholarship, MHRD, New Delhi
Duration: 2016
School Board Member
Organization/Location: Manglayatan University, UP
Duration: 2016–2017
Member, Joint-Coordination Committee
Organization/Location: National Institute of Animal Welfare, Faridabad, Haryana
Duration: 2016–17
School Board Member
Organization/Location: Central University of Punjab, Bhatinda
Duration: 2016–2018
Advisory Committee Member
Organization/Location: UGC-HRD Centre, DDU Gorakhpur University, UP, India
Duration: 2015–2017
Member, Indo-Overseas Fellowship Committee
Organization/Location: DST, India
Duration: 2015
Academic Council Member
Organization/Location: JNU, New Delhi
Duration: 2015
School Board Member
Organization/Location: Dept. of Biotechnology, DDU Gorakhpur University, UP, India
Duration: 2014–2017
Scientific Advisory Committee Member
Organization/Location: Institute of Cytology and Preventive Oncology, ICMR, Noida, UP, India
Duration: 2013
Faculty-in Charge
Organization/Location: Central Laboratory Animal Resources, JNU, New Delhi, India
Duration: 2012
Academic Council Member
Organization/Location: Chhatrapati Shahu Ji Maharaj University, Kanpur, UP, India
Duration: 2012–2015
Moderation Committee Member
Organization/Location: Gujarat State Eligibility Test, Gujarat, India
Duration: 2011, 2012
Chair, Search Committees
Organization/Location: University of Colorado – Bio-fractionation and Cancer Intervention Research
Duration: September 2005, March 2006
Invited Judge
Organization/Location: 17th and 18th Annual Student Research Forum, University of Colorado Health Sciences Center, Denver, CO, USA
Duration: 2002 and 2003
Invited Judge
Organization/Location: Denver Metropolitan Regional Science Fair, Denver, CO, USA
Duration: 2003